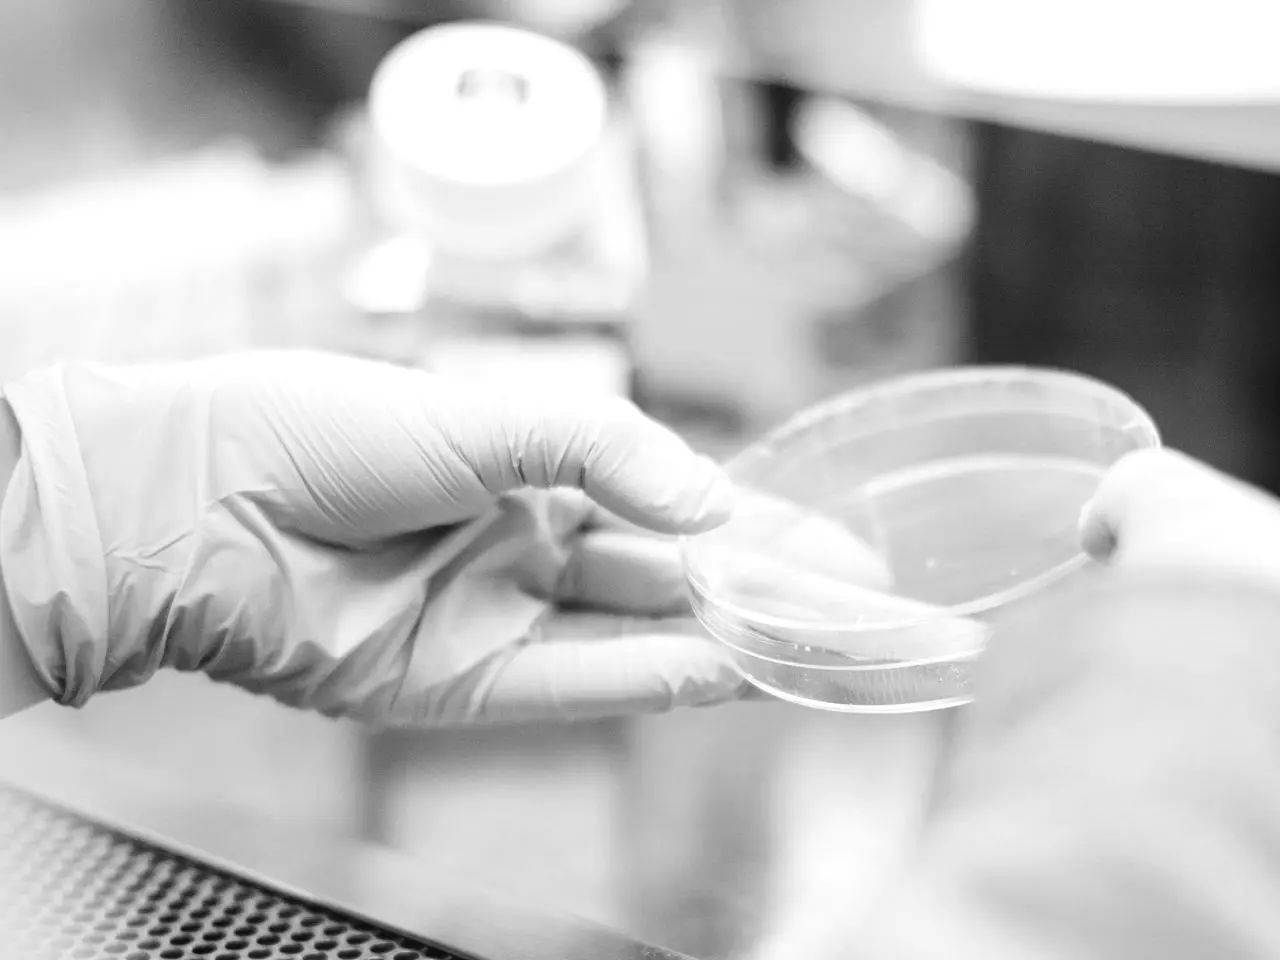

About us
We make recovery smarter.
Powered by science, fueled by real athletes, and designed for those who demand more from their bodies - and their nutrition.
At Smartfish, we fuse Norwegian ingenuity with world-class research to create recovery you can feel. No shortcuts, no gimmicks—just pure performance in every sip.

ORIGINS
Smartfish as a sports drink was created in 2006. Since then we have been a part of elite level athletes' recovery routines, all over the world.
QUALITY
Smartfish is a clean product made from simple, proven ingredients.

EXCELLENCE
Our mission is simple; to create the best recovery drink in the world, and bring it to all athletes who want to perform better, at any level.
MEET OUR TEAM
The passionate people trying to bring better recovery to you.

Kjetil Ramsøy
CEO
Running / Golf
kjetil@smartfish.no

Marius Godø
Marketing
Lifting / Hiking
marius@smartfish.no

Johan Olson
Product
Hiking
johan@smartfish.no

Silje Gjerde
Product
Triathlon
silje@smartfish.no

Johan Wahlqvist
Sales
Hiking / Lifting
johan.wahlqvist@smartfish.no

Erik Espeseth
Partnerships
Water polo
erik.espeseth@smartfish.no

Lily
Customer success
Taekwondo
hi@smartfishsports.com

Sabreen
Customer success
Volleyball
hi@smartfishsports.com
MEET OUR TEAM
The passionate people trying to bring better recovery to you.

Kjetil Ramsøy
CEO
Running / Golf
kjetil@smartfish.no

Marius
Godø
Marketing
Lifting / Hiking
marius@smartfish.no

Johan
Olson
Product
Hiking
johan@smartfish.no

Silje
Gjerde
Product
Triathlon
silje@smartfish.no

Johan Wahlqvist
Sales
Hiking / Lifting
johan.wahlqvist@smartfish.no

Erik Espeseth
Partnerships
Water polo
erik.espeseth@smartfish.no

Lily
Customer success
Taekwondo
hi@smartfishsports.com

Sabreen
Customer success
Volleyball
hi@smartfishsports.com
Smartfish Post Workout v2.2 Raspberry
Taster Pack
199 NOK Free
then 39 NOK per unit / 468 NOK per 12-pack
- Limited offer
- Quick delivery
- Free shipping over 500 NOK
